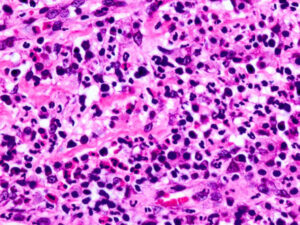
処理

好酸球性肉芽腫は、骨に現れる稀な非癌性腫瘍です。この状態には、体内の特定の免疫細胞の過剰生産が含まれます。
好酸球性肉芽腫の正確な原因は不明であり、治療法は多岐にわたります。
人によっては、この症状は軽度の治療のみで済む場合があります。ただし、他の骨やリンパ節にまで転移する可能性があり、より広範囲の治療が必要になります。
好酸球性肉芽腫のある人の中には治療がまったく必要ない人もおり、医師は患者の痛みの管理を手伝うことができます。
この記事では、好酸球性肉芽腫とその症状と原因について考察します。好酸球性肉芽腫の診断と治療についても検討します。
好酸球性肉芽腫は、骨の非癌性増殖です。これは、医師がランゲルハンス細胞組織球症 (LCH) と呼ぶ、まれな一連の症状の一部です。
これらの状態は、白血球の一種である組織球の過剰産生によって引き起こされます。
組織球が過剰に生成されると、細胞が体の健康なシステムを攻撃し始める可能性があります。これは、好酸球性肉芽腫などの障害や病変を引き起こす可能性があります。
好酸球性肉芽腫はまれです。 Journal of Orthopedics and Traumatologyに掲載された研究では、好酸球性肉芽腫が全骨腫瘍の 1% 未満を占めると指摘しています。
好酸球性肉芽腫は小児および青少年に最も多くみられ、症例の 80% を占めます。そうは言っても、好酸球性肉芽腫はどの年齢でも発生する可能性があります。
好酸球性肉芽腫は体のどこにでも発生する可能性がありますが、増殖は頭蓋骨で最も一般的です。
好酸球性肉芽腫が発生する可能性のあるその他の一般的な骨には、次のようなものがあります。
- 顎
- 肋骨
- 脊椎
- 腕や脚の骨
好酸球性肉芽腫は、1 つまたは数個のスポットで発生する病変または増殖の名前です。場合によっては、これらの病変が神経、リンパ、臓器にまで成長する場合など、他の組織に影響を与える可能性があります。
研究者らは好酸球性肉芽腫の原因を正確には分かっていません。人によっては遺伝との関連がある可能性があります。
遺伝的・希少疾患情報センターによると、ランゲルハンス細胞の遺伝子内の遺伝子変異は、好酸球性肉芽腫の症例の約 50% に存在します。
重要なのは、人々はこれらの突然変異を受け継がず、将来の世代にそれらを伝えることができないということです。
自己免疫疾患、 炎症、その他の種類の LCH などの他の疾患も、好酸球性肉芽腫のリスクに寄与する可能性があります。
さらに、好酸球性肉芽腫または LCH になりやすい人では、転倒や頭部の打撲などの外傷もリスクの一因となる可能性があります。好酸球性肉芽腫の発生において外傷が果たす正確な役割は不明です。
好酸球性肉芽腫の最も顕著な症状は、触ると圧痛を伴う腫瘤の増大です。ただし、好酸球性肉芽腫のある一部の人々では、そのような成長に気付かない場合があります。
好酸球性肉芽腫は、次のような他の症状も引き起こす可能性があります。
- 頭痛
- 熱
- 首や背中の痛み
- 原因不明の皮膚の発疹や発赤
- その領域の可動範囲が制限されている
- 体重に耐えられない
特に腫瘍が他の組織に増殖している場合や神経を圧迫している場合には、他の症状が現れる可能性もあります。
好酸球性肉芽腫の診断には、通常、腫瘍のマーカーを確認し、他の可能性を排除するための臨床検査および画像検査が含まれます。
X 線やCT スキャンなどの画像検査は、医師が成長を特定するのに役立つ場合があります。
ただし、他のいくつかの病気でも画像検査で同様の結果が得られる可能性があるため、医師は腫瘍を確認するために生検を行う必要があります。
組織生検では、成長組織の一部を採取し、状態の特定のマーカーについて検査します。医師は診断を確定するために組織生検を推奨します。
好酸球性肉芽腫の一部の人々では、治療を行わなくても増殖とそれに伴う症状が治ります。これに定められた時間はなく、一部の人は他の人よりも長引く症状に長く対処する場合があります。
医師は、痛みや炎症を軽減するために、メチルプレドニゾロン (メドロール) などのコルチコステロイド注射を処方することがあります。
より重篤な場合には、医師は腫瘍を除去する手術を勧める場合があります。腫瘍が成長していたり、他の臓器や神経を圧迫していたり、重篤な合併症を引き起こす可能性がある場合には、手術が必要になる場合があります。
一部の医師は、特に腫瘍が他の臓器に関与している場合、または脊椎や他の神経を危険にさらしている場合、好酸球性肉芽腫の治療に放射線療法や化学療法などの全身療法の使用を推奨することがあります。
すべての治療には副作用や合併症のリスクが伴います。これらの副作用が心配な方は、治療を開始する前に医師に相談してください。
再発の可能性は常にありますが、好酸球性肉芽腫の多くの場合は再発しません。
研究によると、この状態の再発率は 20% 未満であり、これは好酸球性肉芽腫の症例の 80% 以上で腫瘍が再発しないことを意味します。
好酸球性肉芽腫による合併症の可能性があります。
すべての場合に起こるわけではありませんが、好酸球性肉芽腫は他の骨やリンパ節にまで広がる可能性があります。
大きな腫瘍や骨の間を圧迫する腫瘍は骨折を引き起こす可能性があります。脊椎に腫瘍があると、脊柱に圧力がかかり、椎骨の崩壊やその他の問題が発生する可能性が高くなります。
早期の治療がこれらの合併症の予防に役立つ可能性があります。
好酸球性肉芽腫は、主に小児が罹患する稀な疾患です。腫瘍が増殖する場所によっては、痛みを伴うこともあり、他の症状を引き起こすこともあります。
ステロイド注射やその他の方法による治療が痛みを和らげる場合があります。場合によっては、腫瘍が治療なしで自然に治癒することもありますが、大きい腫瘍や問題のある腫瘍の場合は手術が必要になる場合があります。
厄介な症状に気づいた人は、医師の診察を受けて徹底的な診断を受ける必要があります。症状への対処に困難を抱えている好酸球性肉芽腫のある人は、代替治療法について医師に相談する必要があります。
好酸球性肉芽腫: 知っておくべきことすべて・関連動画
参考文献一覧
- https://rarediseases.info.nih.gov/diseases/6858/langerhans-cell-histiocytosis
- https://www.ncbi.nlm.nih.gov/pmc/articles/PMC4847486/#__ffn_sectitle
- http://www.medicalnewstoday.com/articles/172943
- https://link.springer.com/article/10.1007%2Fs10195-016-0434-7
- https://link.springer.com/article/10.1007/s10195-016-0434-7